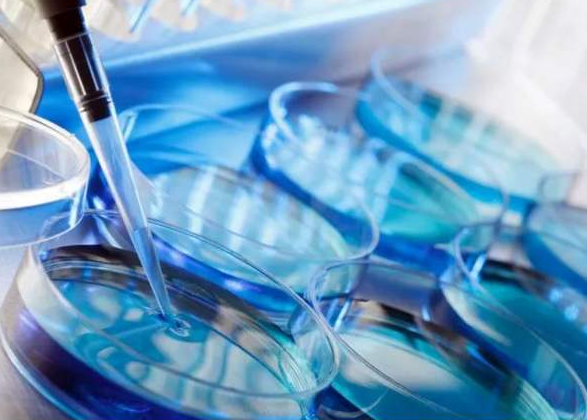
俄罗斯试管婴儿

滔滔顾问|求子多年终于在俄罗斯抱得女儿归!
53岁失独母亲产下一女,只为让家庭重新“活过来
赶在猪年的尾巴,这对“猪宝宝”出生啦!
二婚结扎大龄,俄罗斯试管婴儿怀上宝宝
滔滔顾问|高龄+染色体异常选择俄罗斯试管婴儿生
一路求子披荆斩棘,俄罗斯试管婴儿圆梦
2次试管失败也不放弃,40岁做俄罗斯试管婴儿抱
大龄做俄罗斯试管婴儿只为生个二胎女宝宝
1次人授,移植2次均失败,最后俄罗斯试管婴儿成
丈夫精子畸形率达99%,俄罗斯试管婴儿助力好孕
滔滔顾问:选择俄罗斯试管婴儿喜获龙凤胎
多囊卵巢做俄罗斯试管婴儿成功案例分享
郭女士赴俄罗斯试管婴儿成功怀孕
上海36岁胡女士喜得儿子赴俄罗斯试管婴儿
大龄叶女士分享赴俄试管婴儿感受
流产后还可以做俄罗斯试管婴儿吗?
在国内做试管多次失败,借助俄罗斯试管婴儿好
多囊卵巢做俄罗斯试管婴儿成功怀孕的案例
俄罗斯试管婴儿案例:幸福会迟到,但从不缺席
试管失败后再婚,俄罗斯试管婴儿助孕成功
G小姐选择俄罗斯试管辅助生殖圆生育梦
别再犹豫,听听我们俄罗斯试管婴儿46岁刘姐的自
这辈子,我们注定做一对特殊父母
28岁的人却拥有49岁的卵巢,俄罗斯试管婴儿圆生
一名”卵子成熟障碍“妈妈的俄罗斯试管心路历
湖南姚女士俄罗斯追生男宝
国内两次试管失败,俄罗斯试管婴儿一次成功
大龄求子做俄罗斯试管带健康二胎来报道!
国内试管婴儿多次求子失败,俄罗斯试管婴儿一
输卵管堵塞致不孕,俄罗斯试管婴儿获龙凤胎


Copyright @2017-2020 深圳市滔滔咨询顾问有限公司 版权所有 网站维护:深圳市滔滔咨询顾问有限公司